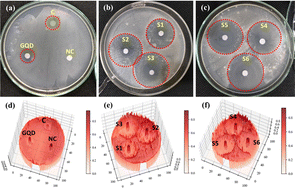

Graphene quantum dot doped viscoelastic lyotropic liquid crystal nanocolloids for antibacterial applications†
Abstract
Graphene quantum dots (GQDs) are prepared and characterized via X-ray diffraction (XRD), UV-Visible spectroscopy, atomic force microscopy (AFM), transmission electron microscopy (TEM) and photoluminescence (PL). GQDs are doped (5 mg and 10 mg) in the lyotropic liquid crystalline (LLC) lamellar and hexagonal phases to prepare GQD/LLC nanocolloids. Polarizing optical microscopy and X-ray diffraction measurement reveals that GQDs do not affect the lamellar and hexagonal LLC structures and may organize on their interface. Pure LLC phases and nanocolloids are studied for steady and dynamic rheological behavior. LLC phases and GQD/LLC nanocolloids possess shear thinning and frequency dependent liquid viscoelastic behavior. A complex moduli study of LLCs and GQD/LLC nanocolloids is carried out which indicates the gel to viscous transition in LLCs and GQD/LLC nanocolloids as a function of frequency. LLC phases and GQD/LLC nanocolloids are tested for antibacterial activity against Listeria ivanovii. The effect of surfactant concentration, LLC phase geometry and GQD concentration has been studied and discussed. A probable mechanism for the strong antimicrobial activity of LLCs and GQD/LLC nanocolloids is presented considering intermolecular interactions. The viscoelastic behavior and strong antibacterial activity (inhibition zone 49.2 mm) of LLCs and GQD/LLC nanocolloids make them valuable candidates for lubrication, cleaning, cosmetics and pharmaceutical applications.

Please wait while we load your content...
Please wait while we load your content...